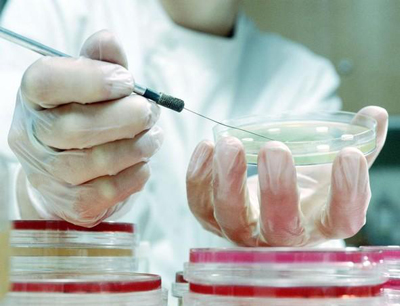
Wirtschaftliche Verwertbarkeit von Forschungsergebnissen wird geprüft.

Neue Chance – der CAST Life Sciences Business Award 2006
Der CAST Life Science Business Award bewertet Ideen für die wirtschaftliche Umsetzung von Forschungsergebnissen. Ausgezeichnet werden jene Einreichungen mit dem höchsten Verwertungspotential.
Unternehmensgründungen sind für das CAST nur ein Weg, über den Forschungsergebnisse wirtschaftlich genützt werden können. Auch durch Lizenzvergaben können ForscherInnen interessante Erlöse oder Drittmitteleinnahmen für ihre Institute und deren Projekte erzielen.
„Den Fachbereich Life Sciences sprechen wir mit dem CAST Business Award aktuell zum zweiten Mal an. Das Geschäftspotential der Lebenswissenschaften an Tirols akademischen Einrichtungen beeindruckt immer wieder“, informiert Christian Mathes vom CAST. Nicht an allen Stellen sei es den ForscherInnen aber durchgängig möglich, dieses Potential auch immer wieder und lückenlos abzufragen. „Mit unserem Wettbewerb geben wir Anstoß zur erneuten Prüfung von Geschäftsmöglichkeiten im Rahmen der letzten Forschungsergebnisse. Überlegungen in diese Richtung können sich sehr rasch mehr als bezahlt machen.“
Einzureichen sind lediglich zwei Dokumente - ein Potentialpapier, das die Verwertungsidee beschreibt und eine Publikation zur Darstellung der zugrunde liegenden Technologie. Das Potentialpapier stellt zur unaufwändigen Erarbeitung alle relevanten Leitfragen zur Verfügung. Es steht auf der CAST-Website unter http://www.cast-tyrol.com/ls-award.html zum Download bereit.
Teilnahmenutzen?
Ideenfindung, Verwertungstraining, die Chance auf Drittmitteleinnahmen, schriftliches Feedback einer unabhängigen Fachjury sowie selbstverständlich alle weiterführenden Gespräche mit den BeraterInnen im CAST. Zusätzlich winken den prämierten Plätzen 1 bis 3 Geldpreise im Gesamtwert von 6.500,- Euro.
Einreichungen zum CAST Life Sciences Business Award 2006 werden ab sofort bis zum 7. März 2006 unter office@cast-tyrol.com entgegengenommen.